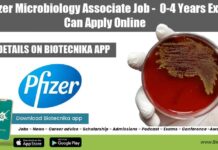
Pfizer Microbiology Associate Job – 0-4 Years Exp Can Apply Online Pfizer Microbiology Job 2022

Microbiology Officer Post Vacant @ Lupin
Lupin Limited is one of India's largest manufacturers of bulk actives and formulations. The principal bulk actives manufactured by it include Rifampicin, Pyrazinamide, Ethambutol...
Earn Upto Rs 6 lakh as Microbiology Associates @ Liva Pharma – Zydus Group...
Liva Pharmaceuticals Limited - a Zydus Group of company is setting up a state-of-art injectable products manufacturing facility at Vadodara (Village : Jarod, Halol...
Openings in Biologics R&D Division @ Aurobindo Pharma ,Hyderabad
Aurobindo Pharma Ltd (APL). APL is a growing Indian multinational pharmaceutical manufacturing firm with turnover of over US$650Mn, with presence in more than 22...
6 Openings in Cell Line Development R&D @ AUROBINDO PHARMA LTD (APL)
Aurobindo Pharma Ltd (APL). APL is a growing Indian multinational pharmaceutical manufacturing firm with turnover of over US$650Mn, with presence in more than 22...
Zika – The Deadliest Virus or an Experiment Gone Wrong ?
Issue Description
The unchecked spread of virus created a situation of panic in major parts of the globe to an extent of a "Global health...
Work in Purification Sciences – Downstream Process Development Biologics R&D @ APL
Aurobindo Pharma Ltd (APL). APL is a growing Indian multinational pharmaceutical manufacturing firm with turnover of over US$650Mn, with presence in more than 22...
Govt of India to recruit 88 Drug Inspectors with Rs 45,000/- pm salary under...
Recruitment to the post of Inspector of Drugs under Directorate of Drugs control
The West Bengal Health Recruitment Board (WBHRB) is responsible for selecting and...
Grab Fellowship of RA & JRF @ DRDE, Ministry of Defence – Salary :...
MINISTRY OF DEFENCE DEFENCE RESEARCH & DEVELOPMENT ESTABLISHMENT
JHANSI ROAD, GWALIOR — 474 002
SELECTION FOR THE FELLOWSHIP OF RA & JRF
The beginning of the...
Celebration time for all PhD Aspirants | Now your Ph.D Degree = Teaching Experience
University Grants Commission
Ministry ol Humon Reource Development, Govf. of lndia
Bahadur Shah Zafar Marg, New Delhi-l10002
D.O.No.F.17-8/2013(PS)
1st March, 2016
Dear Sir/Madam,
The issue regarding counting of the period...
Want to start your own life science company? – Talk by Mr. Shekhar Suman,...
Talk on ENTREPRENEURSHIP - How we can start our own life science industry?
Speaker: Mr. Shekhar Suman, CEO, Managing Director, BioTecNika Info Labs Ltd.
Part 1:
Part 2:
Part...
Jobs at Industrial Research development unit Indian Institute of Technology
Jobs at Industrial Research development unit Indian Institute of Technology
INDIAN INSTITUTE OF TECHNOLOGY DELHI
Industrial Research & Development
Unit Hauz Khas, New Delhi -110016
Advertisement...
Alert ! Notification for GREAT Britain Scholarships India 2016 is out
GREAT Britain Scholarships India 2016
The UK have been welcoming Indian students to its universities and colleges for over 100 years. Prime Ministers Narendra Modi...
Apply for Scholarships of Rs 8 Lakhs + Interest Free Loans to study abroad
Since its inception, the K.C. Mahindra Education trust has promoted education mainly by way of scholarships and grants to deserving and needy students. Some...
Short Term Research Projects @ Centre for Stem Cell Research (a unit of inStem,Bengaluru)
The goal of CSCR is to develop translational and basic stem cell research towards disease biology, novel cellular therapeutics and gene therapy. Scientists (PhD...
BT Sector salary survey 2016: will it pay you the best?
Will biotech pay me the best? Does the life science stream offer enough pay hikes? Will I have a job security? If you are...